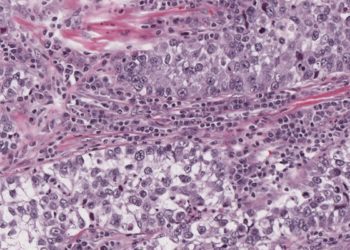
Quick Take: Pembrolizumab Versus Chemotherapy for Previously Untreated, PD-L1-Expressing, Locally Advanced or Metastatic Non-Small-Cell Lung Cancer (KEYNOTE-042)

#VisualAbstract: Atezolizumab in addition to bevacizumab and platinum-based chemotherapy improves survival in metastatic cervical cancer
1. The Atezolizumab group demonstrated significantly greater progression-free and overall survival among patients with metastatic, persistent, or recurrent cervical cancer. ...